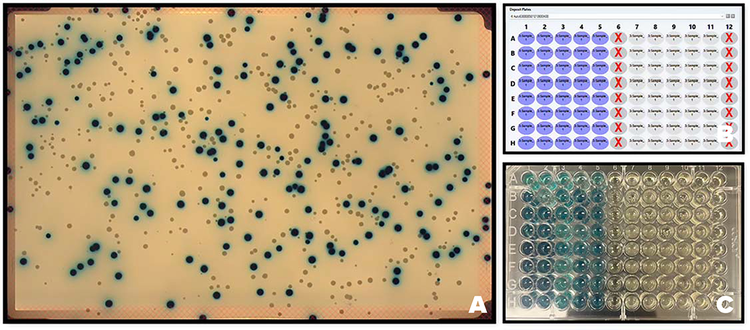
(A) Color Image of blue and white colonies of E. coli. (B) plate map. (C) Destination plate that incubated at 37°C for 16-18 hours

Application Note
The QPix FLEX Microbial Workflow System: Efficient Color-Based Colony Grouping for Microbial Research and Screening
- Precisely identifies and picks colonies based on color and morphology.
- Ensures reproducible results across experiments.
- Differentiates colonies cultured on chromogenic agar media for targeted selection.
- Maintains environmental integrity with contamination-free colony picking.
Introduction
Microbiology laboratories rely on precision, reproducibility, and efficiency to ensure reliable microbial culture analysis. Traditional manual plating and streaking methods, while effective, are prone to variability, labor-intensive handling, and contamination risks. As research demands increase and high-throughput workflows become essential, the need for automated plating and streaking systems has grown significantly.
Automated technologies standardize microbial distribution, minimizing human error while maintaining sterility throughout the inoculation process. These systems optimize colony isolation, plating consistency, and workflow efficiency, enabling microbiologists to scale their experiments and streamline microbial screening processes. Additionally, automation reduces operator fatigue, enhances data integrity, and supports large-scale applications, making it a critical advancement in modern microbiology research and clinical diagnostics.
The QPix® FLEX™ Microbial Colony Picker enhances microbial research by automating colony plating and streaking, and sample traceability, enhancing data integrity and reproducibility and eliminating labor-intensive processes while maintaining a compact design that fits seamlessly on a benchtop or within a hypoxic chamber. By streamlining essential microbial workflows and optimizing sample selection, the QPix FLEX system boosts research efficiency and reduces manual effort, allowing scientists to focus on discovery rather than routine tasks.
This study validates the precision, reliability, and efficiency of the automated plating and streaking capabilities of the QPix FLEX system. By eliminating the variability associated with manual microbial handling, the system ensures consistent colony distribution, enhances single-colony isolation, and maintains a sterile workflow throughout the plating and streaking process.
This technology is particularly beneficial for assays for coliform identification, IPTG/X-Gal for blue-white screening, and specialized microbial media. Automated selection improves experimental reproducibility, data integrity, and high-throughput analysis, enabling robust and scalable microbiological research
High quality color images allow users to carry out a color-based differentiation method. It is based on soluble colorless molecules (called chromogens), when the target organism’s enzyme cleaves the colorless chromogenic conjugate, the chromophore is released, and the microbial colony develops a distinct color.
The QPix FLEX Microbial Colony Picker streamlines microbial research by automating colony picking, reducing manual workload while ensuring efficiency. Its compact design allows seamless integration on a benchtop or within a hypoxic chamber, making it ideal for diverse laboratory environments.
This system features high-resolution color imaging, enabling precise identification and selection of colored microbial colonies. This advanced capability ensures accurate differentiation based on pigmentation, facilitating automated color-based colony grouping.
The Instrument
Hardware features enabling high quality color imaging
This state-of-the-art 20-megapixel CMOS color camera is purpose-built for high-resolution imaging of microbial colonies. It captures true-color images with exceptional clarity, making it ideal for applications in microbiology, synthetic biology, microbiome research and automated colony picking systems.
Key Specifications
- Sensor Type: CMOS (Color)
- Resolution: 5488 × 3672 pixels (20 MP)
- Large Field of View (FOV)
- Image Stitching: Not required – the large sensor and high resolution eliminate the need for stitching, ensuring seamless and artifact-free imaging
Application-Specific Advantages
High-Resolution Colony Detection
- Enables precise visualization of colony morphology, size, color, and edge definition.
- Supports automated image analysis algorithms for colony counting, classification, and phenotypic screening.
True-Color Imaging
- Accurately captures subtle color variations critical for differentiating microbial species or identifying chromogenic reactions.
- Ideal for applications involving colorimetric indicators or pigment-producing strains.
Large Field of View
- Captures full Petri dishes or multi-well plates in a single image, increasing throughput and reducing mechanical movement.
- Enhances consistency and reproducibility in high throughput screening environments.
No Image Stitching Required
- Eliminates stitching artifacts and alignment errors common in tiled imaging systems.
- Reduces processing time and simplifies image acquisition workflows

Figure 1. CMOS color camera on the QPix
Software features that allow for grouping of bacterial colonies based on color
The camera captures true-color images essential for differentiating microbial species based on chromogenic media responses.
Imaging Modes
The camera supports both monochrome and color imaging modes, offering flexibility in visualizing microbial colonies:
- Mono: High-contrast monochrome imaging enhances edge detection and is ideal for identifying subtle morphological differences in non-pigmented colonies.
- Color: Full-color imaging allows for accurate visualization of chromogenic reactions, such as blue-white screening in molecular cloning workflows.
Colony Detection and Grouping
The system supports automated colony detection and grouping based on color and morphology. Key features include
- RGB Histogram Analysis: Provides quantitative data on colony color intensity, supporting automated classification algorithms. The Operator function assigns RGB values to a colony group by referencing the characteristics of a single user-selected colony. This enables automated classification based on color similarity across the designated region.
- Automated Grouping: The QPix FLEX system identifies and classifies colonies based on morphological parameters like compactness, axis ratio, and diameter. The image analysis software includes multiple thresholding algorithms to detect colonies with high fidelity. It detects and groups colonies, facilitating downstream processes such as colony picking or growth rate analysis.
Methods
Automated Picking of Blue/White E. coli Colonies from OmniTrays
Materials
- Source Plate: Undivided OmniTray with LB Agar supplemented with Ampicillin (25ug/ml), IPTG, and X-Gal, containing single blue and white colonies of E. coli.
- Destination Plates: Three 96-well SBS Plates (Costar 3370) containing LB Broth with Ampicillin (25ug/ml), IPTG, and X-Gal.
- Colony Picking System: Sterilizable metal pins programmed to pick blue and white colonies based on user-defined plate map and colony color grouping.
- Sterilization Method: 5-5-5 cycle (5 sec bleach [0.1%], 5 sec water rinse, 5 sec ethanol [70%]).
- Controls: Designated wells to monitor environmental sterility and carry-over contamination.
Protocol
- Colored colonies of E. coli (blue and white) were selected and picked from OmniTray source plates using sterilizable metal pins. Colony selection followed a predefined picking pattern (defined by the destination plate map), ensuring accurate transfer of bacterial colonies to destination plates.
- To maintain sterility, metal pins underwent a 5-5-5 decontamination cycle (5 seconds in 0.1% bleach, 5 seconds in water, and 5 seconds in 70% ethanol) between each picking step, minimizing contamination risks.
- Following colony transfer, destination plates were incubated overnight at 37°C, allowing bacterial growth under optimal conditions.
- Post-incubation, optical density (OD) at 600 nm was measured using a spectrophotometer to evaluate colony growth and picking efficiency.
Automated Picking of Colored Bacterial Colonies (Pink and Blue) from Divided OmniTrays
Materials
- Source Plates: 4-well and 8-well OmniTrays containing ECC CHROMagar with single colonies of E. coli (blue) and Klebsiella aerogenes (pink).
- Destination Plates: Three 96-well SBS Plates (Costar 3370) containing LB Broth.
- Colony Picking System: Automated picking using disposable plastic pins, selecting blue and pink colonies based on colony color grouping and user-defined plate map.
- Controls: Designated wells in destination plates to monitor environmental sterility.
Protocol
- Colored bacterial colonies (blue and pink) from OmniTray source plates were selected and picked using disposable plastic pins, ensuring accurate placement into destination plates.
- The picking run followed a user-defined plate map, ensuring systematic colony grouping based on color differentiation.
- Several wells in destination plates served as negative controls to assess potential environmental contamination.
- Destination plates were incubated overnight at 37°C to support bacterial growth.
- Optical density (OD600) was measured following incubation to evaluate colony growth and picking efficiency.
Results
For the assays we selected two different bacteria strains that show different colors for bacteria depending on expression of b-galactosidase.
Automated Picking of Blue/White E. coli Colonies from OmniTrays
The β-galactosidase assay is used to measure lacZ gene expression in E. coli, a key component of the lac operon. IPTG (Isopropyl β-D-1-thiogalactopyranoside) acts as an inducer, while X-Gal (5-bromo-4-chloro-3-indolyl-β-D-galactopyranoside) serves as a substrate, allowing for visual detection of enzyme activity.
IPTG is a synthetic inducer that binds to and inactivates the lacI repressor, preventing it from blocking transcription of lacZ which leads to the expression of β-galactosidase, an enzyme responsible for hydrolyzing lactose or lactose analogs. IPTG functions independently of lactose metabolism, providing consistent induction levels.
X-Gal is a chromogenic substrate that is cleaved by β-galactosidase, producing an insoluble blue product. Blue colonies indicate active lacZ gene expression, while white colonies suggest repression/lack of lacZ.
The figure(s) below (Figure 2A,2B and 2C) show that the Picking process accurately picked these blue and white E. coli colonies from Undivided OmniTray source plates containing LB agar media supplemented with Ampicillin (25ug/ml), IPTG, and X-Gal, accurately transferring them to 96-well destination plates containing 180 ul of LB Broth with Ampicillin (25ug/ml), IPTG, and X-Gal.
Color detection and Colony grouping was carried out based on color (RGB values) of the colony and the transfer of colonies followed the user-defined destination plate map, ensuring precise placement across wells.
Following overnight incubation at 37°C, optical density (OD600) readings as well as the development/lack of blue color in the destination plate wells confirmed successful bacterial growth of the correct colonies in destination plates.
Figure 2. (A) Color Image of blue and white colonies of E. coli. (B) User defined destination plate map. (C) Example destination plate that has been incubated at 37°C for 16-18 hours
Automated Picking of Colored Bacterial Colonies (Pink and Blue) from Divided OmniTrays
ECC CHROMagar is a selective and chromogenic medium designed for the differentiation of coliform bacteria based on color development, aiding in rapid identification. The medium incorporates substrates targeting β-galactosidase and β-glucuronidase enzymes, allowing distinct colony coloration based on enzymatic activity.
Color-Based Differentiation - E. coli (Blue Colonies) - β-glucuronidase-positive strains hydrolyze the chromogenic substrate, producing a blue coloration. Confirmatory for E. coli presence, distinguishing it from other coliforms. Klebsiella, Enterobacter, Citrobacter spp. (Pink Colonies) - β-galactosidase-positive strains yield pink colonies, differentiating them from E. coli. Identifies non-E. coli coliforms, useful in water testing and clinical microbiology.
The selection process employed by the software successfully picked blue E. coliand pink Klebsiella aerogenes colonies separately from the 4-well and 8-well OmniTray source plates, accurately transferring them to 96-well destination plates. The bacterial colonies were grouped based on their color profile and the transfer of the selected colonies followed the user-defined plate map, ensuring accurate placement into destination wells.
Following overnight incubation at 37°C, optical density (OD600) readings confirmed successful bacterial growth in destination plates, with high recovery rates for Klebsiella aerogenes and moderate growth for E. coli. Negative control wells remained free of bacterial growth, validating the efficacy of the sterile picking process and confirming the absence of environmental contamination.

Figure 3. (A) Grouping of blue E. coli and pink Klebsiella aerogenes colonies plated on 8 region OmniTrays

Figure 4. (B) Grouping of blue E. coli and pink Klebsiella aerogenes colonies plated on 4 region OmniTrays (C) User defined platemap.
Conclusion
The QPix FLEX automated colony picking workflow demonstrated high accuracy and reproducibility in isolating bacterial colonies based on chromogenic differentiation. In both β-galactosidase–driven blue/white screening using X-Gal/IPTG and chromogenic classification on ECC CHROMagar, the system reliably discriminated between colony phenotypes using RGB based grouping and transferred them with precision to 96-well destination plates.
Overnight incubation and OD₆₀₀ measurements validated the viability of the selected clones, with expected color development (in blue/white screening using X-Gal/IPTG) reaffirming correct phenotypic selection. Notably, the sterile picking process maintained environmental integrity, as evidenced by negative control outcomes.
These findings affirm the suitability of the QPix FLEX system for color-based colony selection in molecular biology workflows, enabling efficient screening, library construction, and strain isolation with minimal manual intervention.
Discussion
This study demonstrates the versatility and precision of the QPix FLEX system in automating phenotype-based microbial screening. By combining RGB-based colony discrimination with high-throughput liquid handling, the platform successfully supported two distinct colorimetric workflows: classical blue/white selection on IPTG/X-Gal–supplemented media and species differentiation using ECC CHROMagar.
In the blue/white assay, the QPix FLEX reliably distinguished lacZ-expressing (blue) from non-expressing (white) E. coli colonies. Color-based picking and placement into user-defined destination plate maps allowed downstream phenotypic confirmation via both OD₆₀₀ measurement and chromogenic readout. The maintenance of color phenotype post-incubation confirmed genotype integrity across the transfer process and highlighted the system’s suitability for molecular cloning workflows involving recombinant screening. These results validate this method as an optimal fit for applications such as:
- Cloning and subcloning workflows
- Library construction and screening
- CRISPR plasmid validation
- Reporter gene assays
Similarly, colony selection from ECC CHROMagar plates demonstrated the QPix FLEX platform’s adaptability to complex chromogenic outputs. The software effectively grouped E. coli (blue) and Klebsiella aerogenes (pink) colonies based on subtle hue variations, underscoring the platform’s fine-tuned vision capabilities. The high recovery and growth rates— especially for Klebsiella—alongside sterility in negative controls, reinforce the reliability and precision of the automated picking workflow(s) for microbiological applications beyond recombinant screening, such as:
- Water and food quality testing
- Environmental microbiome surveillance
- Microbial isolate tracking in synthetic biology
Importantly, both assays benefited from end-to-end traceability and consistent well-to-well reproducibility. The integration of customizable source and destination mapping allowed scalable throughput and flexible experimental design. Notably, the sterile workflow maintained environmental cleanliness, as evidenced by the absence of growth in no-template controls.